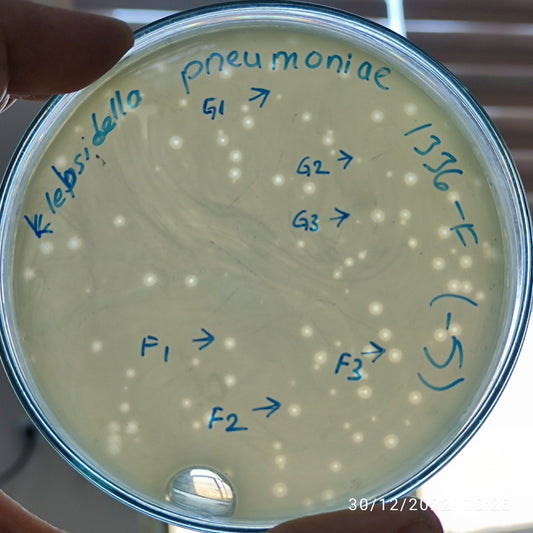
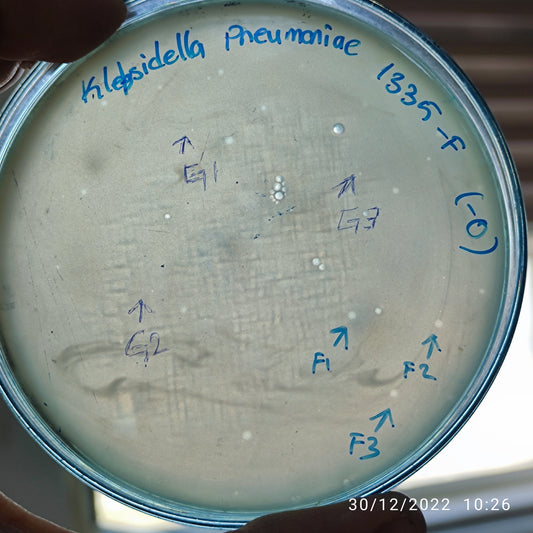
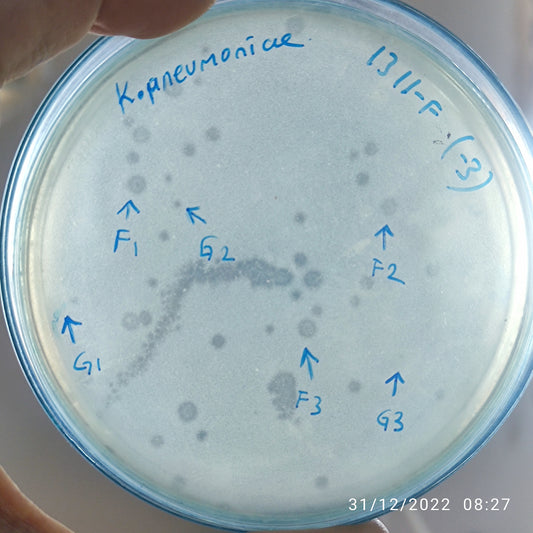

-
Klebsiella pneumoniae bacteriophage 181343F
Regular price $500.00 USDRegular priceUnit price per -
Klebsiella pneumoniae bacteriophage 181342F
Regular price $500.00 USDRegular priceUnit price per -
Klebsiella pneumoniae bacteriophage 181337F
Regular price $650.00 USDRegular priceUnit price per -
Klebsiella pneumoniae bacteriophage 181336G
Regular price $500.00 USDRegular priceUnit price per -
Klebsiella pneumoniae bacteriophage 181336F
Regular price $500.00 USDRegular priceUnit price per -
Klebsiella pneumoniae bacteriophage 181335G
Regular price $500.00 USDRegular priceUnit price per -
Klebsiella pneumoniae bacteriophage 181335F
Regular price $500.00 USDRegular priceUnit price per -
Klebsiella pneumoniae bacteriophage 181329F
Regular price $500.00 USDRegular priceUnit price per -
Klebsiella pneumoniae bacteriophage 181323F
Regular price $500.00 USDRegular priceUnit price per -
Klebsiella pneumoniae bacteriophage 181321F
Regular price $500.00 USDRegular priceUnit price per -
Klebsiella pneumoniae bacteriophage 181319F
Regular price $650.00 USDRegular priceUnit price per -
Klebsiella pneumoniae bacteriophage 181318F
Regular price $600.00 USDRegular priceUnit price per -
Klebsiella pneumoniae bacteriophage 181311G
Regular price $500.00 USDRegular priceUnit price per -
Klebsiella pneumoniae bacteriophage 181311F
Regular price $500.00 USDRegular priceUnit price per -
Klebsiella pneumoniae bacteriophage 181310F
Regular price $600.00 USDRegular priceUnit price per -
Klebsiella pneumoniae bacteriophage 181308F
Regular price $500.00 USDRegular priceUnit price per